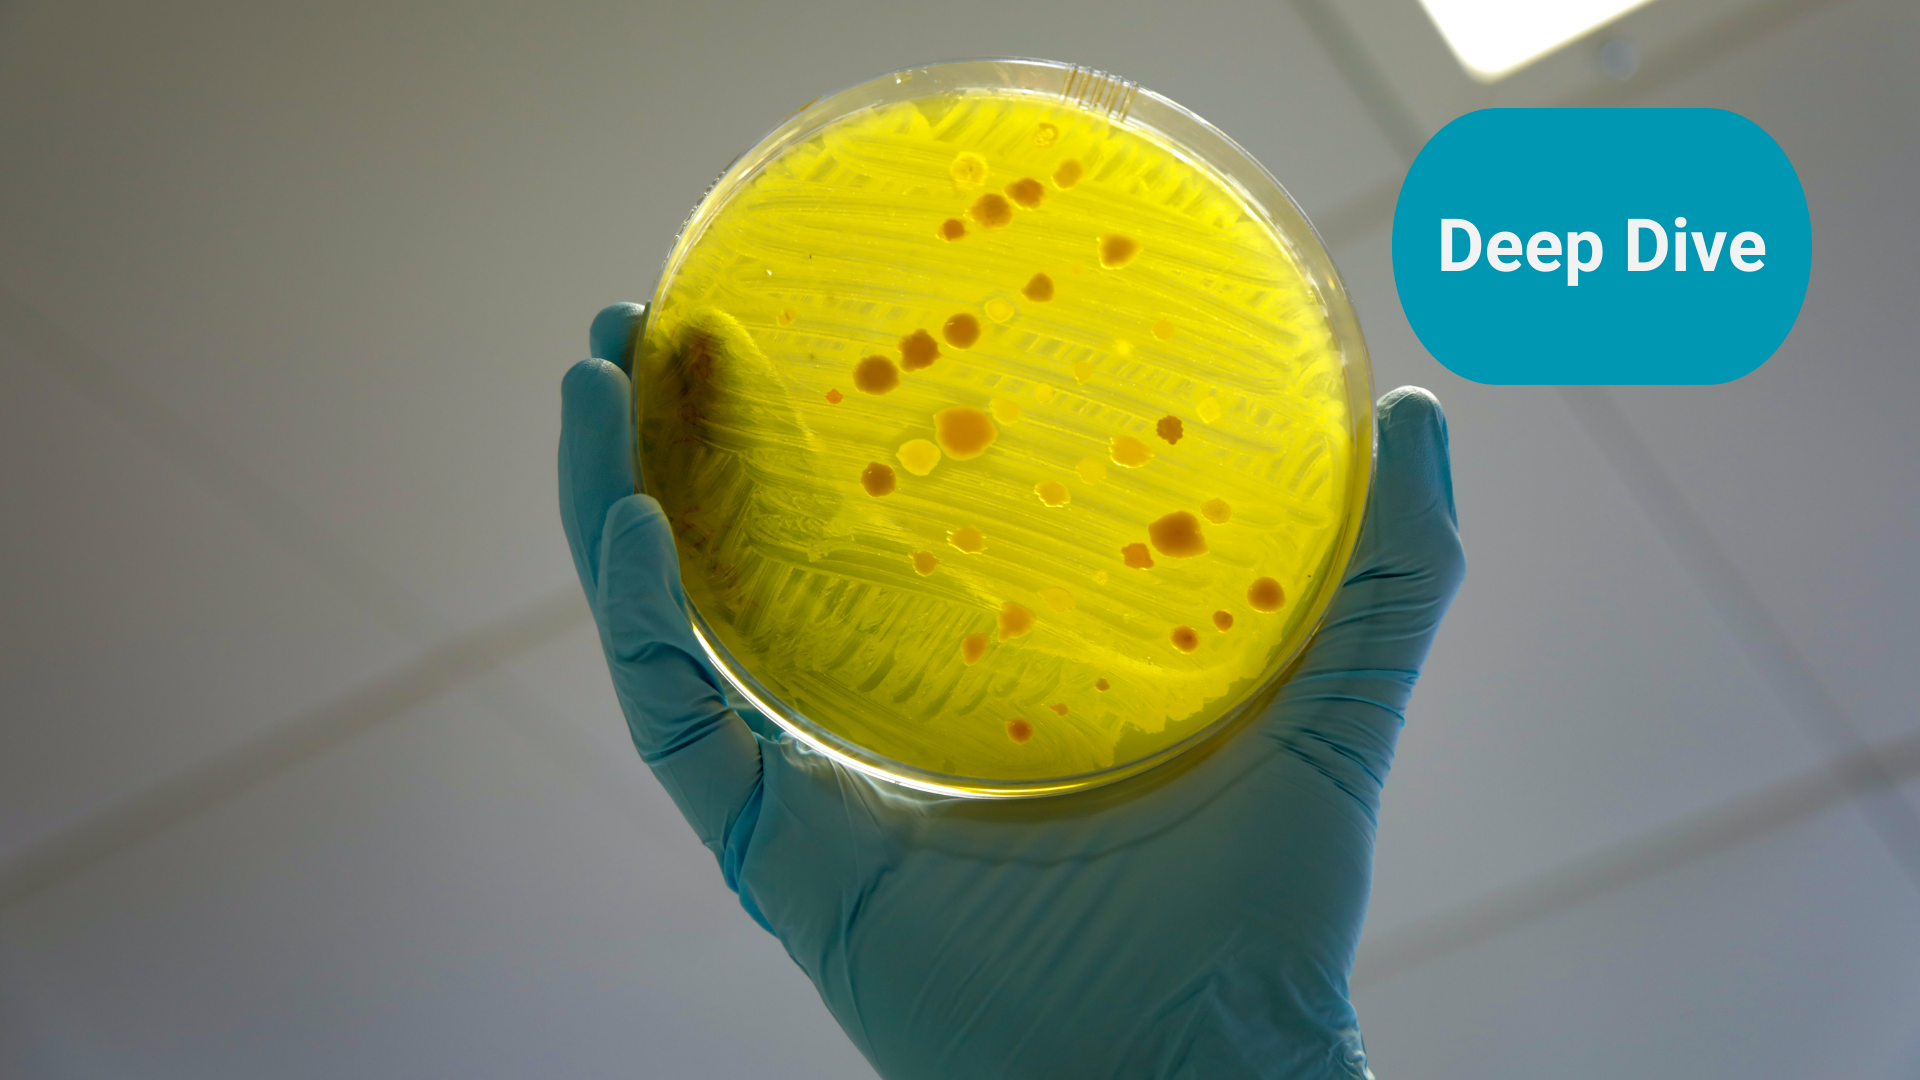

AMR - Spoiling the party with physics and material science
Antimicrobial Resistance (AMR) is a macro threat to the sustainability of the human race and other species. Bringing together different solutions we should be able to continue to enjoy the benefits of our microbe partners whilst avoiding their darker side.
Summary: A dragonfly, copper, blue light, organised lightning, spider silk and ozone. I discuss how physics and material science can also help us in the ongoing fight against antimicrobial resistance (AMR). I shall also explain why pharmacological solutions need to be used with the appropriate care by reminiscing about the time that my spotty face led to a spotty gut and people thought I was taking Viagra (true story).
Why this is important: Physics and material science is an area that gets far less focus in the mainstream than pharmacological and behavioural solutions.
The big theme: Antimicrobial Resistance (AMR) is a macro threat to the sustainability of the human race and other species. It is of a similar level to that of the worst impacts of climate change or biodiversity loss and is inextricably linked. Bringing together biological, behavioural, and physical solutions with appropriately incentivising funding we should be able to continue to enjoy the benefits of our microbe partners whilst avoiding their darker side. This is potentially a massive, if complex, theme for those who care about sustainability; the potential goes well beyond the pharmaceutical industry.

The details
Antibiotics and other antisepsis measures revolutionised surgery and healthcare. Highly invasive operations, such as gut surgery and joint replacements all depend on antibiotics to prevent infection and be successful. Certain treatments which render the immune system less effective, such as chemotherapy, are made viable by the support provided by antibiotics. Where previously catching certain infections was pretty much a death sentence, antibiotics and other antimicrobials provided hope.
However, some microbes have adapted, either over the long term through genetic mutation or using existing defence mechanisms, and are now able to resist attempts to stop them being infectious and causing disease. That adaptation is helped when antimicrobials, especially antibiotics, are over- or inappropriately used. Not only does that mean antimicrobials could become less effective at treating/preventing infections, but they may also stop working altogether.
There are some infections that defy even powerful antibiotics. You have most likely heard of a hospital superbug called MRSA - “Methicillin-Resistant Staphylococcus Aureus”
Left unchecked, AMR could become the major source of death globally.

"Antimicrobial resistance poses a catastrophic threat. If we don’t act now, any one of us could go into hospital in 20 years for minor surgery and die because of an ordinary infection that can’t be treated by antibiotics."
Professor Dame Sally Davies, UK Special Envoy on AMR
AMR is exacerbated and inextricably linked with other systemic risks. For example, climate change is causing thawing Arctic permafrost could release potentially fatal microbes for which we have no treatment. Climate change is changing habitats and bringing diseases out of traditional areas into non-traditional ones: There have been 570 cases of West Nile Virus in Europe in 2022 and more than 40 native cases of dengue in several French regions. Changes in climate have caused a migration of the Aedes invasive mosquito.

However, there are ways forward. There are a number of different angles for attacking the problem of AMR and in this blog I shall discuss one of those: The physical.
Before we dive in, if the area of AMR is new to you and you want to get up to speed have a look at the primer I produced. In it I give an overview of microbes and in particular bacteria before going on to describe how resistance occurs and is propagated, before finally introducing some possible solutions to help combat AMR.
In the primer I highlight that whilst a natural focus for efforts would be to “find more antibiotics” if at the high level we are “running out of antibiotics that work” it is only one avenue: biological or pharmacological.
There are also ways to reduce the chance for microbes to develop resistance by reducing the need to use them in the first place through behavioural changes and stewardship (using antimicrobials appropriately), improving the availability of clean water and access to sanitation and reducing waste antimicrobials from entering water systems.
Not all microbes are bad. In fact some are beneficial to us and even necessary for our bodies to function properly. So the question has to be how do we stop microbes from being harmful to us?
There are three main ways:
- Remove the microbe (or stop it being there in the first place)
- Kill the microbe (speaks for itself)
- Stop it becoming pathogenic (stop it causing disease)
Even if we can't kill the microbe, if we can stop it causing disease then we can still avoid the worst impacts of resistance.
I have been covering AMR for a few years now and it is encouraging to see the recent acceleration in interest and awareness with more and more events and reports being published.
I recently attended one such event hosted by Aviva Investors where an excellent report was launched highlighting the triple threat of AMR, climate change and biodiversity loss, how they are interlinked and the 'big asks' to help avert the catastrophe that Professor Dame Sally Davies spoke of.
Often these events are really useful in understanding where the gaps in the knowledge are or in understanding the connections that people are making. It was encouraging to see that the 'unsexy' area of hygiene and behavioural changes were seen as important. In particular the critical need to address shortfalls in the provision of clean water and sanitation in both developed and developing nations as a nexus point for solutions, addressing the triple systemic threats of AMR, climate change and biodiversity loss. That is an area I shall touch on in an upcoming blog.
One area that doesn't seem to get as much attention is how material science and physics can help to mitigate the impacts of AMR. Through our understanding of the way in which microbes interact with us, there may be ways to disrupt them physically and stop them being pathogenic, for example stopping them forming biofilms.
Before we look at some innovative physical solutions ranging from biomimicry in material science to electricity and light, let me first explain why pharmacological solutions need to be used with the appropriate care by reminiscing about the time that I had a spotty face and people thought I was taking Viagra.
A spotty face that led to a spotty gut
As a teenager I went through puberty in the way that most boys did and do. My voice and various other parts of me dropped at the most inopportune moments and I was short, short, short, short, short and then overnight shot up six inches in height leaving me looking and walking like Gollum from The Lord of the Rings (I still have stretch marks on my thighs from that growth spurt, and yes it wasn't quite 'overnight' but you get my drift).
One thing I missed out on was teenage acne. Sure I had the occasional 'Mount Vesuvius' but largely I was blessed with relatively unblemished skin. However, wind the clock forward about fifteen years and the demons of puberty joined forces with the stresses of working on a trading floor to announce themselves as adult acne or more specifically acne rosacea and seborrheic dermatitis. I started to field questions such as "what are you allergic to?" and "ooh did you forget your sun cream?" and on very rare occasions "I didn't realise you could get sunburnt."
I went to see a specialist and was prescribed low dose doxycycline which was a common treatment as it attacked the bacteria on the skin that caused the breakouts.
Unfortunately some antibiotics can kill relatively indiscriminately. Doxycycline for example had thought be bacteriostatic, that is it stopped bacteria from reproducing, but in fact research has shown that it and some other commonly taken antibiotics can kill useful bacteria in the gut.
My own experience of feeling sluggish and having pretty regular stomach upsets attests to that and I eventually stopped taking them. I later found that dietary changes had a dramatic impact, in particular reducing to a bear minimum the amount of dairy that I was consuming. Now my skin only breaks out on 'cheat days.'
So antibiotics are incredibly useful in rendering harmful bacteria ineffective, but that can often come at a cost.
Oh I almost forgot. I used a Pfizer branded doxycycline called Vibramycin which was next to Viagra on the alphabetically organised pharmacist's shelf. Whether intentionally or not sometimes the 'wrong box' got brought down.


Physical solutions
As well as chemical compounds that can fight bacteria and other microbes, sometimes physical properties can be used to destroy or disrupt the action of harmful microbes.
Most often, microbes are harmful when they club together to form biofilms. The National Institutes of Health (NIH) revealed that among all microbial and chronic infections, 65% and 80%, respectively, are associated with biofilm formation. In general, bacterial biofilms show resistance against the human immune system, as well as against antibiotics. So what is a biofilm? First of all a quick reminder of the anatomy of a bacterium:

The process of biofilm formation consists of a number of steps illustrated in the diagram below. Initially the individual bacteria are floating around using their flagella to move around. They start to attach to a surface (which could be living or non-living) using flagella and fimbriae and after layering up this leads to the formation of a micro-colony. As more and more bacteria join you start to get a mushroom shaped three dimensional structure. Finally the biofilm matrix is partly broken down and some bacteria escape to repeat the process again in another location. During the formation of a biofilm several species of bacteria communicate with one another through a process called 'quorum sensing' where genes are expressed when there is a certain number of other bacteria in close proximity, i.e. density.

Probably the most common form of biofilm we are all familiar with is dental plaque which is the root cause (no pun intended) of tooth decay. However, biofilms can also form on medical devices, implants and other things we put in or on our bodies. Contact lenses, prosthetic joints and catheters are examples.
Physical-based solutions, such as surface coatings, filter systems and even light and electricity can be used to make it harder for bacteria to form colonies or biofilms. Once a biofilm is formed it is hard to penetrate and so chemicals or antibiotics can fail to destroy many of the bacteria with the surviving ones able to develop resistance. These solutions are mainly about “stopping microbes becoming pathogenic.”
Let's look at some examples.
If we travel by my dragonfly
If his lyrics are to be believed, Jimi Hendrix used to travel to a Seattle nightclub where he sometimes played in his early career by dragonfly. No doubt about it dragonflies are beautiful and mesmerising insects. They are one of nature's wonders. There is much we can learn and have learned from nature. Biomimicry is the emulation of nature to solve complex human problems.
Dragonfly and cicada wings have antibacterial and antifungal properties. Their surfaces have tiny spikes or 'nanopillars' which are of a similar size to bacteria cells. They physically disrupt the membranes of the bacteria inducing oxidative stress and destroying them. They can also prevent biofilms from forming by preventing the individual bacteria from .

Scientists at RMIT University in Australia led by Professor Elena Ivanova discovered these properties a decade ago and have been refining their application, most recently with teams from Tokyo Metropolitan University, the Kaiteki Institute and Mitsubishi Chemical. They have created a material which, once the manufacturing process can be scaled up, could produce "shelf life extending materials for [food and beverage] products and protection for pharmaceuticals."

This opens up the possibility of creating antibacterial and antiviral coatings or surfaces for example for use in hospitals. A team from the University of Technology in Brisbane, Australia etched disks of aluminium 6063 alloy (commonly used in hospital and medical equipment as well as doorframes and window panels) with sodium hydroxide for up to 3 hours changing their smooth, hydrophobic surface into a ridged, hydrophilic surface. When tested they found that P. aeruginosa and S. aureus bacteria were inactivated after 3 hours on the surface, while the viability of common respiratory viruses dropped within 2 hours - better results than with plastic or smooth aluminium surfaces. Potentially this could be applied to other common or public areas in airports, shops and public transport like trains, buses or taxis.
And Jimi probably took a taxi.
Simple and ancient materials
Regular readers will know what big fans we are of using and repurposing ancient innovations to solve modern problems. Certain materials possess antimicrobial properties intrinsically. The antimicrobial effect of copper has been known for centuries, and ongoing research is being conducted on the use of copper-coated hard and soft surfaces to reduce infections. Copper has been shown to be effective on both MRSA and VRE and correlated with quicker wound healing.
How copper (and its alloys) work was described by Professor Bill Keevil from the University of Southampton in a 2012 paper. When microbes land on the surface, copper ions are released that "prevent cell respiration, punch holes in the bacterial cell membrane or disrupt the viral coat, and destroy the DNA and RNA inside." With the DNA and RNA destroyed there is no information to 'pass onto the next generation or neighbouring bacteria' and so resistance to the copper can't be developed.
Cost is normally a factor in changing fixtures and fittings in hospitals for copper
There are a number of interesting potential applications. A team of researchers from the University of Tokyo, the Korea Research Institute of Bioscience and Biotechnology and the Center for Emergent Matter Science & Thin-Film Device Laboratory RIKEN 2-1 Hirosawa has developed an antimicrobial second skin using copper nanomesh.
Longer term it could conceivably be used as a surface cover for smartphones and other mobile computing devices.

Let there be light!
A number of studies have found that blue light may be a possible physical solution for decontaminating hospital environments as well as localised infections. It works by generating reactive oxygen species ('ROS') by the bacteria themselves when exposed to the light, particularly when that light is at wavelengths of between 460nm to 470nm causing the bacteria cells to undergo 'oxidative stress' ultimately resulting in the cells dying.
Scientists from Boston University's College of Engineering found that blue light phtolysis could temporarily weaken MRSA such that hydrogen peroxide could then eradicate sizable portions of MRSA colonies.

A team from Harvard Medical School found that bacteria in surface wounds could be killed by first applying carvacrol (derived from thyme and oregano) and then shining blue light on it. They found that this approach cured MRSA and A. baumanni infections in third-degree burn wounds in mice. Few or no adverse effects were noted, and no antibacterial resistance occurred after 20 applications. More studies are needed but it could be a promising treatment for humans.
Organised Lightning
The impact of electricity (or 'organised lightning' as George Carlin put it) on bacteria has been known for years. In 1972 Rowley from the University of Missouri, demonstrated that applying a direct current could stop bacteria reproducing. Later studies would demonstrate bacteriocidal effects too.
More recently, researchers from the University of Arkansas have found that a current of less than 100 millionths of an amp, only requiring a voltage of less than 1.5 volts applied for thirty minutes could kill bacteria. It works by creating holes in the bacteria's outer membranes such that proteins and other small molecules leak out.
That means that electricity from a household battery or a small solar panel no more than a centimetre square could be used to sterilise surfaces and help water purification.
Given how low the voltage is, could it provide a technique for sterilising objects such as doorknobs?
Does whatever a spider can
When Peter Parker was bitten by a radioactive spider he woke up the next morning with the ability to "do whatever a spider can" including spinning webs (of any size) and "catching thieves just like flies" but we never seemed to hear about his ability to stop biofilms forming.
Scientists at the Nanjing Tech University in China created a textile woven from artificial Spider silk material which was found to stop biofilms forming as well as helping human tissue to regenerate in wounds. This could lead to the development of coatings potentially eliminating the growth of biofilms on an array of items, including medical equipment. When combined with the power of current antibiotics it could be even more potent.

More recently a team led by Woong-Jin Lee from Yonsei University in Seoul, Korea showed that a fibroin bioadhesive could be made from spider silk which accelerated wound closure and healing of broken bones. Not only was the adhesive stronger than existing products but also injectable.
Other materials can have coatings that can help repel or render harmful microbes ineffective. A smart dental implant, developed by Penn's School of Dental Medicine and the Department of Electrical and Computer Engineering, Temple University, Philadelphia, can resist bacterial growth by using a barium titanate-infused material to repel the negatively charged cell walls of bacteria and stop them forming colonies.
A number of surfaces for both food preparation and medical uses can be infused with antibacterial compounds to reduce the risk of bacteria becoming pathogenic.
I have already highlighted that one area where the risk of biofilms forming is high is on medial devices and implants. Depositing 'zwitterionic' materials (they have equal positive and negative charges) onto the surface of such devices can prevent microbes from attaching and proliferating as biofilms on surfaces.
O, O, O it's magic
Ozone has been known to be not only antibacterial but also capable of inactivating a number of viruses. A 2015 study found that four patients suffering from acute Ebola fully recovered within four days when treated with ozone therapy with no long-term complications.
More recently, applying ozone directly to wounds has been found to stimulate tissue repair and research has been ongoing to develop cost-effective wearable devices to administer the therapy.
Ozone may be used to remove antibiotic and other pharmaceutical residues from water. The TalTech research group from the Laboratory of Environmental Technology in Tallinn, Estonia found that ozone-activated persulfate was effective at removing residues from the combination antibiotic sulfamethoxazole/trimethoprim.
Ozone has also been used as a washing alternative for clothing. For example, Advanced Clothing Solutions uses ozone to kill germs and viruses including E.coli, S.aureus and coronavirus.
Conclusion
Antimicrobial Resistance (AMR) is a macro threat to the sustainability of the human race and other species. It is of a similar level to that of the worst impacts of climate change.
There has been much focus on improving the ability and incentive to discover new antibiotics and pharmacological antimicrobials and this remains crucial. It is only one pathway for us though.
Bringing together biological/pharmacological, behavioural and physical solutions with appropriately incentivising funding we should be able to continue to enjoy the benefits of our microbe partners whilst avoiding their darker side.
Something a little more bespoke?
Get in touch if there is a particular topic you would like us to write on. Just for you.
Contact us
Please read: important legal stuff.
